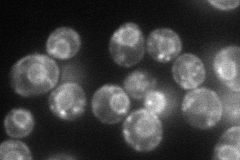
YBR265W
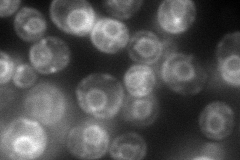
YBR265W
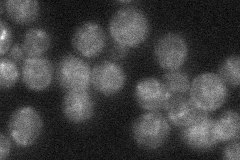
YBR265W

View description
3-ketosphinganine reductase, catalyzes the second step in phytosphingosine synthesis, essential for growth in the absence of exogenous dihydrosphingosine or phytosphingosine, member of short chain dehydrogenase/reductase protein family
Localization:
Intensity:
Fold change:
Significance:
-
C’ GFP library in SD

ER25.73 -
N' NOP1pr-GFP in SD
ER,punctate75.7911 -
N' TEF2pr-mCherry in SD
ER,punctate99.3913 -
N' NATIVEpr-GFP in SD
ambiguous,ER25.9133 -
N' TEF2pr-VC and Cyto-VN in SD

below threshold27.2404 -
C’ GFP library in SD+DTT

ER23.510.91No -
C’ GFP library in SD+H2O2

ER25.410.98No -
C’ GFP library in Starvation Media

ER27.731.07No -
C’ GFP library on the background of Pup2-DaMP

ER -
C’ GFP library on the background of CCT mutant

ER19.52940.758868No
